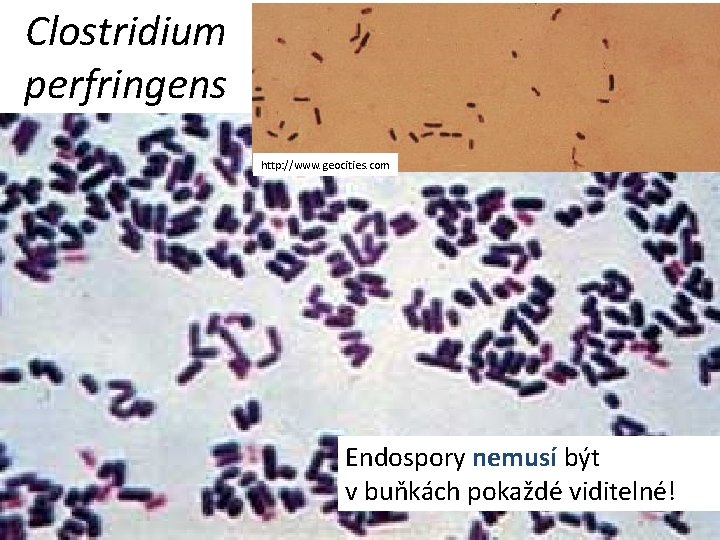
Clostridium perfringens http: //www. geocities. com Endospory nemusí být v buňkách pokaždé viditelné!
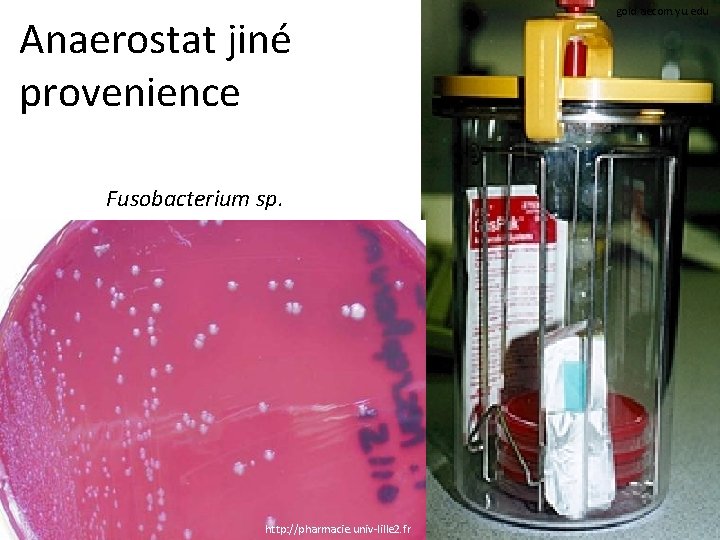
Anaerostat jiné provenience Fusobacterium sp. http: //pharmacie. univ-lille 2. fr gold. aecom. yu. edu
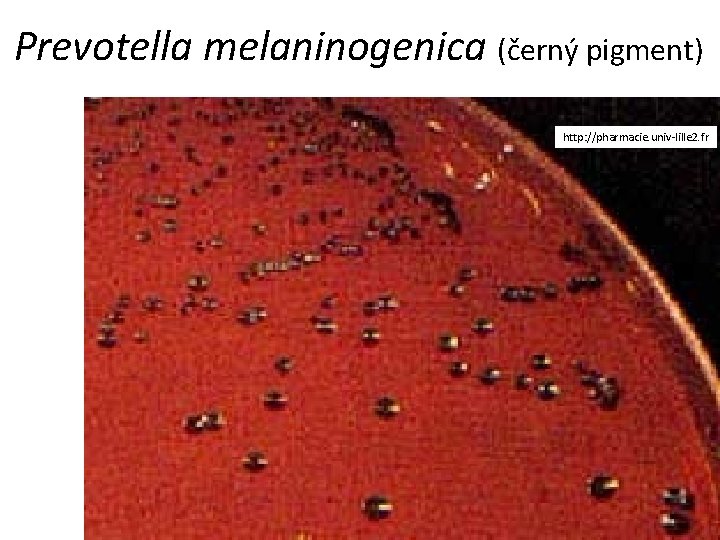
Prevotella melaninogenica (černý pigment) http: //pharmacie. univ-lille 2. fr

Mikrobiologick stav uvd NA STOP PACHATELE L Dl

Mikrobiologický ústav uvádí NA STOPĚ PACHATELE L Díl sedmý: Anaerobní pachatelé

Přehled témat Patogeny s komplikovanou diagnostikou Klostridia – klinická charakteristika Nesporulující anaeroby a laktobacily – charakteristika Vztah bakterií ke kyslíku (opakování z jarního semestru) Diagnostika anaerobů a získávání anaerobiózy Bonusový materiál: povídání o očkování

Patogeny s komplikovanou diagnostikou

Ještě než začneme… • …měli bychom si něco uvědomit. Doteď (P 01 až P 06) jsme si povídali o převážně (s výjimkou např. Neisseria gonorrhoeae, brucel či legionel) bakteriích, na které není třeba nijak zvlášť myslet. • Klinik prostě pošle vzorek „na kultivaci“, a ono z něj „něco vyroste“. • S tím už je ale KONEC! Dál už nás čekají jen mikroby, pro které tohle neplatí.

Takže: • Pokud chce klinik, aby byl jeho vzorek prověřen na přítomnost anaerobů, mykobakterií či aktinomycet, musí to uvést na průvodce, protože se musí použít speciální postupy. • U dalších původců (třeba spirochet či chlamydií) se navíc zpravidla odebírá sérum a provádí se nepřímý průkaz. • To si pamatujte hlavně pro budoucí praxi. Zkoušku třeba nějak uděláte – ale tohle byste si měli uvědomit třeba i za dvacet let!

Klostridia – klinická charakteristika

Příběh první • Paní K. byla celé dny k vidění v zahradě. Byl to její velký koníček. Jednou se zranila na ruce, kvůli špičatému zbytku rostliny, ukrytému v půdě. Šla ke svému obvodnímu lékaři. • Obvodní lékař lokálně ošetřil ránu, a pak jí doporučil přeočkování proti jisté vážné chorobě. • Kdyby tu chorobu dostala, bylo by to velmi nebezpečné, mohlo by to znamenat i křeče jejího těla.

Neurotoxická klostridia • Zločinec, který hrozil paní K. , byl Clostridium tetani, původce tetanu. Nemoc je typická místním drobným zánětem a celotělovým šířením toxinu, který vyvolává křeče. • Další neurotoxické klostridium je Clostridium botulinum, původce botulismu. Zde původce vůbec nevstupuje do těla. Jen jeho toxin vstupuje do těla (zpravidla z nedostatečně upraveného konzervovaného masa) a opět účinkuje jako neurotoxin, zde však vyvolává obrny. http: //sarasbioblogspot. cz/2010/10/clostridium-tetani. html

Tetanus www 2. bc. ca. us

Tetanus www 2. bc. ca. us

medinfo. ufl. edu Tetanický muž

Trismus (křeč čelistních svalů) http: //pharmacie. u niv-lille 2. fr

Botulismus www 2. bc. ca. us

Typický vzhled jazyka při botulismu http: //pharmacie. univ-lille 2. fr

Botox: použití jedu Clostridium botulinum pro mladistvý vzhled www. fda. gov

http: //pharmacie. univ-lille 2. fr Příběh druhý • M. , kosovský Albánec, se rozhodl, že navštíví svého bratrance v sousední vesnici. Pole, přes které se vydal, již mělo být odminováno. Přesto se jedna nevybuchlá mina našla. Střepina, špinavá od bláta, se M. zasekla hluboko do stehna. • Za několik dní byl M. přijat do jedné z polních nemocnic. Stehno měl zduřelé a při poklepu byl slyšitelný zvuk praskajících bublinek. M. byl hned operován.

http: //www. cdc. gov/foodsafety/clostridium-perfingens. htm Viníkem je tentokrát • Clostridium perfringens, jeden z původců plynaté sněti (spolu s C. novyi, C. septicum aj. ). • Plynatá sněť je typické válečné onemocnění. Může se však vyskytnout i v dobách míru, například při živelných pohromách. • Klostridia plynatých snětí – respektive jejich enterotoxiny – se také uplatňují jako patogeny ve střevě (někdy způsobují i nekrotizující kolitidy)

Vznik plynaté sněti http: //pharmacie. univ-lille 2. fr

Příběh třetí • Pan K. ležel už třetí týden v nemocnici pro bakteriální zánět kostní dřeně. Zánět mu léčili klindamycinem. • Náhle pan K. dostal těžký průjem. Na oddělení zrovna neměli metronidazol, a tak sáhli po staré metodě: dali panu K. vypít ampulku vankomycinu, antibiotika, které se normálně podává pouze injekčně, protože se nevstřebává ze střeva.

Viníkem je Clostridium difficile, respektive jeho toxin. • Tento mikrob se vyskytuje ve střevě celkem běžně, problém však je, když začne produkovat toxin, a především, když mu někdo odstraní konkurenci a on se přemnoží. • Odstranění konkurence způsobí nejčastěji léčba některými typy antibiotik, dříve nejčastěji linkosamidy, avšak bohužel dnes i řada dalších, například aminopeniciliny. Linkosamidy jsou účinné proti většině striktně anaerobních bakterií, nikoli však proti C. difficile. • Dnes se k léčbě používá nejčastěji bakteriální chemoterapeutikum metronidazol. Existuje také možnost fekální bakterioterapie („transplantace stolice“). •

Clostridium difficile a jeho činnost I www. cdiff-support. co. uk

Clostridium difficile a jeho činnost II www. cdiff-support. co. uk

www. zuova. cz

Pseudomembranózní kolitida http: //www. csgh. info/arch_detail. php? stat=397

Klostridia – přehled C. tetani Původce tetanu C. botulinum Producent botulotoxinu Clostridium perfringens, C. septicum, C. welchii a aj. C. difficile Klostridia plynatých snětí (+ enteropatogenita) Enteropatogenní Je potřeba si uvědomit, že i klostridia se úplně normálně podílejí na běžné střevní mikroflóře. Problém nastává, pokud se přemnoží, dostanou tam, kam nemají, vyskytne se kmen produkující velké množství toxinu apod.

Nesporulující anaeroby (a laktobacily) – klinická charakteristika

http: //www. vetbook. org/wiki/dog/index. php/Prevotella_spp Příběh čtvrtý • Paní R. byla přijata pro horečnatý stav a intenzivní bolesti břicha. • Zobrazovací metody ukázaly na absces malé pánve. Ukázaly však také nádor na děložním čípku – později se ukázalo že jde o karcinom. • U paní R. se naštěstí podařilo operačně vyřešit nejdříve absces a poté i nádor, byť za cenu provedení hysterektomie. Metastázy se naštěstí neobjevily.

Viníkem je… Směs striktně anaerobních, ale i fakultativně anaerobních bakterií. • Tato směs se zřejmě vyskytovala v pochvě paní R. , aniž by jí činila sebemenší problémy. • Nádor však porušil anatomickou bariéru, a mikroby se dostaly do míst, kde způsobily absces. • Nesporulující striktně anaerobní mikroby mají vzhledem ke svým vlastnostem velmi omezené možnosti přenosu velká část infekcí je endogenního původu. •

Společné charakteristiky nesporulujících anaerobů • Vyskytují se jako běžná flóra: • • www. microbes-edu. org v tlustém střevě – 99 % celkového objemu mikrobů (cca jeden kilogram) v ústech – život díky biofilmu – nemají v něm přímý přístup ke vzduchu, které by je ohrožoval v pochvě – nejsou přítomny u všech žen, ale u asi 70 % žen se anaeroby vyskytují; pokud se zde ovšem přemnoží, jde o dysmikrobii, kterou je nutno léčit Při zánětu obvykle neexistuje jeden původce, ale uplatňuje se směs. Někdy se používá termín „Veillonova flóra“.

Anaeroby v těle gsbs. utmb. edu

Anaerobní infekce z ústní dutiny aapredbook. aappublications. org

Novorozenecká anaerobní pneumonie Bacteroides fragilis pneumonia in newborn (B. fragilis isolated from the placenta and blood culture from the newborn). Anaerobic cultures were obtained because of a faecal odour in the amniotic fluid. aapredbook. aappublications. org

Gingivostomatitis: Prevotella gingivalis www. mamagums. com

Přehled nesporulujících anaerobů (u člověka nejběžnější druhy) Koky G+ Peptococcus Peptostreptococcus Tyčinky Propionibacterium*** Eubacterium G- Veillonella Fusobacterium, Leptotrichia* Bacteroides, Prevotella, Porphyromonas** *se zašpičatělými konci **s rovnými konci tyčinky ***není stoprocentní anaerob

Příběh pátý • Paní N. měla chronické problémy s poševními záněty. • Lokální antibiotika ve formě vaginálních globulí či krému s aplikátorem vždy pomohla jen dočasně, pak se patogeny zase vrátily. • Nakonec jí gynekolog doporučil probiotický preparát se směsí „dobrých“ bakterií, které zajistí návrat normální poševní mikroflóry a nedovolí patogenům opětovné množení. • A hlavní „dobrá bakterie“ byl…

Lactobacillus acidophilus, „Döderleinův bacil“ • Laktobacily jsou poměrně robustní grampozitivní tyčinky. Jmenují se laktobacily, protože fermentují různé substráty (glukózu, laktózu) na kyselinu mléčnou (laktát). • Laktobacily jsou nejdůležitější součásní vaginální mikroflóry, a jsou také důležitou součástí mikroflóry střevní. • Laktobacily nejsou anaerobní bakterie. Nicméně, jelikož jsou často mikroaerofilní, nejsou zpravidla schopny růst za normální atmosféry. Na druhou stranu, nedokonalá anaerobióza našich běžných anaerostatů a anaerobních boxů jim umožňuje růst lépe.

Vztah bakterií ke kyslíku (opakování)

Připomeňme si, za jakých podmínek rostou jaké bakterie Prostředí Normální O 2 CO 2 Bez O 2 Striktní aeroby Fakultativ. anaeroby Aerotolorantní bakt. Mikroaerofilní bakt. Kapnofilní bakterie Striktní anaeroby ano ano ne* ano ne ne ne ano ano (ano) ano ne ne ne* ano** *V praxi někdy vyrostou – běžně dosahovaná anaerobióza není dokonalá **V praxi někdy nevyrostou – běžně dosahovaná anaerobióza není dokonalá. Takové bakterie (EOS – Extremely oxygen sensitive) běžně nelze kultivovat

Co jsme znali doteď • V prakticích P 1 až P 6 jsme se seznámili se čtyřmi skupinami mikrobů, které rostou za aerobních podmínek – ať už jsou striktně aerobní jako např. pseudomonády, nebo fakultativně anaerobní jako třeba Escherichia coli.

Nyní si přidáme další čtyři skupiny • Každá z oněch čtyř skupin má totiž svoje anaerobní „bratříčky“. Jejich vlastnosti se výrazně liší od aerobních bakterií a naopak vykazují některé společné charakteristiky. Vymyká se jen rod Clostridium, protože umí tvořit spory.

Diagnostika anaerobů a získávání anaerobiózy

Jak pátrat po těch divných týpcích z Anaerobní čtvrti – I • Mikroskopie: Má větší význam než u aerobů, vzhledem k morfologické různorodosti. • Kultivace: Je nutno zajistit anaerobiózu pomocí anaerostatů či anaerobních boxů. U tekutých půd postačuje přelití parafinem. Používá se VL (viande levure) bujón, VL krevní agar a různé speciální půdy. • Biochemie: kataláza a oxidáza většinou negativní, možné vzájemné rozlišení biochemicky, i analýza plynů chromatogafií (jsou biochemicky aktivní). • Antigenní analýza a nepřímý průkaz se v diagnostice anaerobů příliš nepoužívají.

Odběr a transport vzorku na průkaz anaerobů • Přednost má tekutý vzorek, např. hnis, nejlépe zaslaný ve stříkačce s krytkou (po odstříknutí přebytečného vzduchu)* • Pokud se zasílá výtěr, je nezbytné, aby byl zanořen v transportní půdě; stačí ale běžná, např. Amiesova půda • Lze také domluvit s laboratoří naočkování vzorku přímo na půdy např. peroperačně *dříve doporučený postup, kdy se na stříkačce ponechala jehla a zabodla do gumové zátky se již z bezpečnostních důvodů nedoporučuje

Mikroskopie anaerobních bakterií • Podezřelé kmeny barvíme normálním způsobem podle Grama, rozlišujeme na koky a tyčinky, G+ a G • Anaerobní tyčinky jsou někdy velice různotvaré – v jednom preparátu najdete útvary od vláknitých až po prakticky kokovité

Poznámka k mikroskopii anaerobů: různé tvary anaerobů • Studenti někdy zaměňují spóru (útvar, který je neprobarvený, resp. jen slabě se rýsují jeho okraje) a ztluštění tyčinky (které se vyskytuje u některých tyčinek, které jsou nesporulující a zpravidla gramnegativní). • U skutečných sporulujících mikrobů má význam sledovat umístění spór. U Clostridium tetani je spóra terminální (na konci umístěná). Skutečná endospora Rozšíření http: //cs. wikipedia. org/wiki/Spora_%28 bakterie%29

Clostridium tetani http: //www. geocities. com http: //www. docstoc. com/docs/123452532/clostridium-tetni Terminální endospora

http: //www. extension. org/pages/13215/clostridium-botulinum Clostridium botulinum http: //www 2. bc. ca. us/bio 16/20_Nervpictures. htm
Clostridium perfringens http: //www. geocities. com Endospory nemusí být v buňkách pokaždé viditelné!

http: //depts. washington. edu/molmicdx/mdx/tests/cdiff. shtml Clostridium difficile http: //medecinepharmacie. univ-fcomte. fr

Clostridium difficile www. straightfromthedoc. com

Bacteroides fragilis http: //www. geocities. com Bacterloides fragilis

Bacteroides sp. Dříve se používal pro tyto útvary název „Sphaerophorus necrophorus“, tedy „Kulonoš smrtonosný“ Mikrobiologický ústav, foto O. Z.

Fusobacterium sp. http: //www. geocities. com

Peptostreptococcus sp. Peptostreptokoky jsou anaerobní G+ koky v řetízcích, zatímco peptokoky jsou anaerobní G+ koky ve shlucích. http: //www. geocities. com

Veillonella sp. Veillonella je velmi drobný anaerobní G– kůček http: //www. primer. ru

Kultivace anaerobních bakterií • Anaerobní bakterie rostou často v drobných, nepravidelných koloniích, které mají někdy výběžkaté okraje. Typický je pro ně také značný zápach. • Aerobní kultivace na krevním agaru umožňuje růst striktně aerobních a fakultativně anaerobních bakterií. Když tu tedy bakterie neroste, avšak roste na anaerobních půdách, je to striktní anaerob. Pro kultivaci anaerobů používáme VL krevní agar (v praxi mu říkáme prostě VL agar).

Poznámka ke kultivaci anaerobů: Jak získat anaerobiózu • Mechanicky – VL bujony přelijeme parafinovým olejem • Fyzikálně – v anaerobním boxu se nahradí vzduch směsí anaerobních plynů, vháněných z bomby • Chemicky – v anaerostatu se: – z organických kyselin tvoří vodík a CO 2 – v druhé fázi na palladiovém katalyzátoru reaguje vodík s kyslíkem za vzniku vody, takže se kyslík spotřebovává

Přelévání VL-bujonů parafinem Mikrobiologický ústav, foto O. Z.

Anaerobní box zdroj anaerobních plynů prostor pro vkládání misek Mikrobiologický ústav, foto O. Z. vstupy pro ruce personálu

Anaerostat (princip) Palladiový kalalyzátor (pod víčkem) nezbytný pro druhou fázi reakce Generátor anaerobiózy (sáček s chemikáliemi) nutný pro celou reakci Mikrobiologický ústav, foto O. Z.

Anaerostat (podrobný popis) šroubovací uzávěr tlakový ventil vzduchotěsné víčko palladiový katalyzátor (pod víčkem) konstrukce pro ukládání Petriho misek Generátor anaerobiózy (sáček s chemikáliemi) Mikrobiologický ústav, foto O. Z.
Anaerostat jiné provenience Fusobacterium sp. http: //pharmacie. univ-lille 2. fr gold. aecom. yu. edu

Morfologie kolonií anaerobních bakterií • Klostridia mívají poměrně velké, nepravidelné, smrduté kolonie. • Jiné anaerobní bakterie mívají spíše drobné kolonie. • Některé anaerobní bakterie (Prevotella melaninogenica) mají pigmentované kolonie. • Je potřeba počítat s tím, že kultivace trvá déle než u aerobů (2 dny až týden, u některých ještě déle).

Mikrobiologický Clostridium perfringens

Clostridium septicum http: //pharmacie. univ-lille 2. fr
Prevotella melaninogenica (černý pigment) http: //pharmacie. univ-lille 2. fr

Peptostreptococcus magnus www. zuova. cz www. szu. cz Peptostreptococcus anaerobius

Biochemické rozlišení • Používají se různé testy, v našich podmínkách především ANAEROtest 23 Lachema. Kmen A Kmen B Zapíšeme výsledky jednotlivých reakcí („+“ nebo „-“) a spočítáme oktalový kód. Výsledek se určí podle kódové knihy. POZOR – kódová kniha je rozdělená na několik částí podle morfologie anaerobních bakterií. Je třeba hledat v té správné části kódové knihy

http: //pharmacie. univ-lille 2. fr Ukázky různých zahraničních testů pro identifikaci anaerobů www. microbes-edu. org

Testy antibiotické citlivosti • Lékem volby u většiny anaerobů je opět klasický penicilin. Rezistentní je však rod Bacteroides (v užším slova smyslu – rody Prevotella a Porphyromonas, které se z něj kdysi odštěpily, jsou citlivé). • Antibiotická citlivost se u anaerobů prováděla difusním diskovým testem (nikoli na MH, ale na VL krevním agaru), nyní se ale zpravidla používá E-test (hodnota MIC se odečítá v místě, kde se kříží okraj zóny s testovacím proužkem)

Detekce toxinu I: průkaz lecitinázy • Tvorba lecitinázy se projeví precipitací kmene na žloutkovém agaru. Protože však lecitináz je mnoho a nás zajímá pouze lecitináza Clostridium perfringens, prověřujeme, zda je lecitináza inhibovatelná specifickým antitoxinem. „Negativní I“ vůbec neprodukuje lecitinázu. „Negativní II“ produkuje, ale nějakou jinou, než nás zajímá

Detekce toxinu II: průkaz tetanového a botulického toxinu pokusem na zvířeti • Pokus na zvířeti se používá u tetanu a botulismu. • U tetanu se myš svíjí v křeči, u botulismu jsou naopak patrné parézy. Tetanická myš microvet. arizona. edu

Průkaz toxinu pokusem na zvířeti • Prohlédněte si obrázek tetanické myši. Obrázek Petra Ondrovčíka (1959– 2007) Graficky upraveno. www. biotox. cz Podobně jako myš se do opistotonu dostává i pacient

Vzhled pokusného zvířete je sledován i u jiných stavů, např. u botulismu. • U botulismu převažují parézy, nikoli spasmy.

Detekce toxinu III: Imunochromatografický test na průkaz toxinu Clostridium difficile • Imunochromatografické testy jsou založeny na navazování jednotlivých komponent, podobně jako u reakcí ELISA či a imunofluorescence. • Nejklasičtějším příkladem je těhotenský test. • Princip byl vysvětlen v praktiku J 08. • V případě testování kmenů Clostridium difficile produkujících toxin se na rozdíl od některých jiných případů testují paralelně toxiny A a B a navíc ještě antigen tohoto klostridia Pokud je pozitivní průkaz toxinu i antigenu, jsou viditelné tečky uprostřed a dvě čárky. V případě pozitivního pouze antigenu jedna čárka. Validní, ale zcela negativní test signalizuje přítomnost teček bez přítomnosti čárek.

Princip (jen pro ilustraci) + – Testovací oblast Kontrolní oblast

Praktické pátrání po anaerobech – příklad u vaginálních výtěrů • Je-li u vaginálních výtěrů požadována anaerobní kultivace, používá se VL agar s disky vankomycinu a amikacinu. Anaerobní bakterie zpravidla rostou mezi těmito dvěma disky. • Kromě případných bakterií zpravidla vidíme mnoho kolonií poševních laktobacilů, mikroaerofilních bakterií často nalézaných v poševních výtěrech. Při běžné aerobní kultivaci je nacházíme zřídka. • Naše nedokonalá anaerobióza tedy umožňuje i růst mikroaerofilních mikrobů.

Konec http: //pharmacie. univ-lille 2. fr

Bonusový materiál: povídání o očkování

Aktivní imunizace • Aktivní imunizace = očkování: do organismu je vnesena očkovací látka, obsahující antigen. Tělo je antigenem "vyprovokováno" a vytváří protilátky. • Očkování proti TBC – výjimka: cílem zde není vyvolat tvorbu protilátek, ale tvorbu buněčné imunity, což souvisí se zvláštními mechanismy u TBC infekce.

Očkovací látky proti bakteriálním nákazám I • Očkování živými bakteriemi se používá u tuberkulózy. Očkování se provádí ihned po narození a nepřeočkovává se, jen se kontroluje stav imunity (tzv. tuberkulínovým testem). • Bakteriny – celé usmrcené bakterie. Například očkování proti černému kašli, způsobenému Bordetella pertussis.

Očkovací látky proti bakteriálním nákazám II • Anatoxiny neboli toxoidy – tam, kde bakterie škodí hlavně prostřednictvím toxinů (jedů). Anatoxin = jed zbavený jedovatosti (toxicity), který si zachovává antigenní působení. Např. očkování proti tetanu a záškrtu. • Čištěné povrchové antigeny (např. polysacharidové), např. Haemophilus influenzae b, Neisseria meningitidis aj.

Očkovací látky proti virovým nákazám • Živé vakcíny – pěstují se oslabené kmeny virů na buněčných kulturách. U oslabených osob mohou vyvolat různé reakce. Spalničky, zarděnky, příušnice; na lžičce podávaná (Ig. A!!) – dětská obrna (Sabin). • Usmrcený virus – virus je vypěstován a poté usmrcen, nejčastěji formaldehydem. Klíšťová encefalitida, žloutenka A, injekční dětská obrna (Salk) – nyní podáváno. • Chemovakcíny – antigen byl získán „chemickou“ cestou (rekombinací DNA). Např. látka Engerix proti hepatitidě B.

Druhy očkování • Základní očkování – dnes již deset očkování tzv. očkovacího kalendáře • Očkování mimo tento základ, např. – Očkování u profesionálního rizika (hepatitida B u zdravotníků, klíšťová encefalitida u lesníků) – Očkování před cestou (žlutá zimnice…) – Očkování pro oslabené (chřipka) – Očkování profylaktické (vzteklina) – Očkování na přání (chřipka, klíšťová encefalitida)

Očkovací kalendář platný od roku 2010 dříve http: //www. vasedeti. cz/vychova/pece-o-miminko/pozor-na-zmeny-vockovacim-kalendari/

Očkování proti TBC • Očkovalo se samostatně, u nás první týden po narození (nyní se očkují jen rizikové děti). • Během dalších let se provádí tzv. tuberkulinová zkouška – kožní test buněčné imunity. Pokud je negativní, očkuje se znovu. Pozor, očkovat ty, kteří imunitu mají, by bylo nebezpečné. • Nedávné zrušení očkování je důsledkem snížení počtu případů. Na druhou stranu někteří se zrušením nesouhlasí, například upozorňují, že očkování do jisté míry chránilo i proti mykobakteriózám (způsobeným netuberkulózními mykobakteriemi).

Očkování proti TBC www. indoindians. com/health/vaccine. htm Calmette-Guérinův bacil (odtud pojem „kalmetizace“)

Očkování proti tetanu • Očkuje se v kombinaci spolu s dalšími pěti chorobami. • Kromě přeočkování hexavakcínou v prvním roce života se v 11– 12 letech přeočkovává i trivakcínou (klasické „dite-pe“). • Látka je anatoxin (toxin zbavený toxicity, ale se zachovanou antigenní účinností). • Tetanus dnes není běžný, ale je natolik závažný, že očkování je stále namístě. Tetanická klostridia se i dnes vyskytují ve střevě zvířat, a tedy i v zemi, pokud by se neočkovalo, bylo by riziko velké.

Očkování proti záškrtu Očkování proti černému kašli • Očkuje se v kombinaci. • Kromě přeočkování hexavakcínou v prvním roce života se v 11– 12 letech přeočkovává i trivakcínou (klasické „di-te-pe“). • Látka proti záškrtu je anatoxin, proti černému kašli jde o směs anatoxinu a dalších antigenů. • Záškrt je stále aktuální, zejména vzhledem k migraci z postsovětských republik, kde se difterie i pertuse stále občas vyskytují. • U náš se oboje vyskytuje občasně.

Očkování proti „Hib“ • Jde o očkování proti Haemophilus influenzae, a to proti opouzdřeným kmenům s pouzderným typem b. • Látka je čištěný polysacharid. • Očkuje se v kombinaci. • Bylo zavedeno před několika lety a po jeho zavedení významně poklesl počet invazivních hemofilových infekcí předškoláků (záněty mozkových blan, plic, příklopky hltanové).

Očkování proti hepatitidě B • Očkuje se v kombinaci (u těch, kteří nebyli očkováni jako malé děti, i samostatně nebo dohromady s hepatitidou A). Očkovací látka je vakcína vyrobená rekombinantně na kvasince Saccharomyces cerevisiae. • Další z poměrně nedávno zavedených očkování – i dříve ovšem používáno, ale jen u rizikových skupin (např. děti HBs. Ag pozitivních matek) či profesního rizika (zdravotníci).

Očkování proti dětské obrně • Nedávno se přešlo na injekční Salkovu vakcínu (usmrcený virus) která umožňuje kombinaci s několika jinými vakcínami (hexavakcína). • Přeočkování v 10– 11 letech se očkuje samostatně. • Dříve se používala se perorální Sabinova vakcína – živý virus. Je velmi účinná, ale má riziko komplikací, i když jen nepatrné. • U nás se dětská obrna nevyskytuje, ale vyskytuje se v Asii a nedávno i v JV Evropě, takže cíl, kterým je celosvětová eradikace tohoto závažného onemocnění, je ještě daleko.

http: //en. wikipedia. org/wiki/Image: Stamp-ctc-polio-vaccine. jpg Salk a Sabin http: //www. hindu. com/seta

Očkování proti spalničkám • Očkuje se v trojici se zarděnkami a příušnicemi, ve všech třech případech jde o živé viry. • U těchto očkování se nejčastěji objevují pochyby, jestli je nutné a vhodné. • Ovšem spalničky jsou poměrně nepříjemné, pro dítě bolestivé onemocnění, a způsobují ekonomické ztráty (absence rodiče v práci). • Existuje i riziko sklerotizující spalničkové panencefalitidy (zánětu mozku), hlavně u dospělých. Je velmi vzácné, ale závažné.

Očkování proti zarděnkám • Také zarděnky v době před očkováním znamenaly velké ekonomické ztráty, komplikace pro školy a školky apod. • Zarděnky jsou také nebezpečné u těhotných, kde existuje riziko potratu u infikovaných žen. • Proto byly v 80. letech očkovány nejprve dívky ve 12 letech a pak i všechny dvouleté děti.

Očkování proti příušnicím • Pro příušnice platí totéž co pro předchozí dvě choroby. • Zatímco zarděnky byly nebezpečné těhotným dámám, příušnice hrozí spíše pánům (dospělým) – riziko zánětu varlat (orchitidy), vedoucí až k neplodnosti.

Očkování „MMR“ (measles, mumps, rubella = spalničky, zarděnky, příušnice http: //www. brown. edu/Courses/Bio_160/Projects 2000/MMR/mmrmeaslesvaccine. htm www. sciencemuseum. org. uk

Očkování proti chřipce • V poslední době populárnější než dříve, vzhledem k riziku tzv. aviární chřipky (H 5 N 1) a prasečí chřipky (H 1 N 1). • U chřipky je ovšem třeba počítat s. rizikem antigenního driftu (drobné změny antigenní struktury) a shiftu (větší antigenní posuny). Proto očkování nezanechává trvalou imunitu a musí se každý rok obnovovat.

Očkování proti chřipce whyfiles. org/195 bird_flu/4. html

Očkování proti klíšťové encefalitidě • Často žádané očkování – ovšem lidé většinou nechávají očkovat děti, ačkoli onemocnění probíhá závažněji u dospělých. Do 6 let se nedoporučuje. • Očkuje se dvěmi dávkami zpravidla v. zimním období, třetí („boosterová“) dávka následuje další zimu. Doporučuje se po třech letech přeočkovat. • Nechrání samozřejmě proti borelióze.

http: //www. kimtran. net Další očkování • • • 1 proti meningokokové infekci (nyní již i B) proti pneumokokové infekci (nyní hrazeno) proti planým neštovicím proti různým tropickým chorobám proti rakovině cervixu (hrazeno 13 letým dívkám) proti HIV, borrelióze, malárii (výzkum)

Nežádoucí účinky očkování • Bylo by nezodpovědné tajit, že očkování může mít i nežádoucí následky. • Pravda je i to, že mohou být i příčinou smrti. • Příčinou nepříznivé reakce může být: – alergie na některou složku očkovací látky (nejen na antigen, ale i na látky pomocné) – podráždění imunitního systému, zejména u osob s narušenou imunitou – u oslabených virů a bakterií může i proběhnout vlastní onemocnění, ovšem velmi slabě

Jsou důvodem proč neočkovat? • Díky očkování již lidé často zapomínají na dobu, kdy po ulicích chodili lidé s aktivní tuberkulózou, kteří byli hrozbou pro ostatní. Zapomínají na tělesně postižené děti po prodělané dětské obrně. • I zdánlivě „neškodné“ nemoci, jako jsou třeba příušnice či zarděnky, hrozí komplikacemi, poškozením plodu u těhotných a podobně.

Rizika a přínosy • Každý zdravotnický postup přináší riziko selhání či nežádoucích účinků. • Proto také existuje velmi přísná kontrola ze strany státu (MZd, SÚKL, hygienik…) i stavovských organizací (ČLK) a odborných společností (ČLS JEP), aby nebyly používány postupy „non lege artis“, čili v nesouladu se současnými poznatky vědeckého poznání. • Postupy, na kterých se všechny zmíněné instituce shodnou, mají jednoznačně prokázaný větší přínos než riziko.

Opačný extrém • Je ale i opačný extrém: někteří lidé pod tlakem reklamy vyžadují očkování, která pro ně či jejich děti nejsou vhodná. • Například u dětí do šesti let je zbytečné zatěžovat jejich organismus očkováním proti klíšťové encefalitidě. Takové děti jsou neustále prohlíženy rodiči, takže riziko, že by klíště bylo dost dlouho přisáté je zanedbatelné. U malých dětí má onemocnění zpravidla navíc lehký průběh. • Věřme autoritám, pokud něco doporučují nebo nedoporučují, většinou k tomu mají dobré důvody.

„Mám právo nenechat své dítě naočkovat“. • Není to pravda. Dítě není majetkem matky. Tak jako matka nemá právo dítě týrat nebo ho jen tak přestat posílat do školy, také nemá právo ohrozit jeho zdraví tím, že ho bezdůvodně nenechá očkovat. • Není to pravda dvojnásob. Nenaočkovat dítě znamená ohrozit třeba i cizí dítě, které nemohlo být naočkováno ze zdravotních důvodů. Čím menší je proočkovanost populace, tím větší je riziko vzniku epidemického výskytu nemoci.

Další aktuální informace o očkování… • …naleznete na stránkách www. vakciny. net

http: //cs. wikipedia. org/wiki/Tetanus v kostce • Může vzniknout jako endogenní (střevo či vagina) nebo exogenní (spórami infikované hlubší znečištěné či zhmožděné rány, v ráně klíčení spór) infekce. • Za vlastní klinické projevy je zodpovědný tetanický toxin, který blokuje inhibici motorických neuronů (brání uvolňování mediátorů této inhibice). • Projevuje se tonickými křečemi příčně pruhovaného svalstva. • Žvýkací svaly (trismus), mimické svaly • Spasmy svalů trupu, svalové ruptury, zlomeniny • Postižení dýchacích svalů, srdeční zástava
- Slides: 108